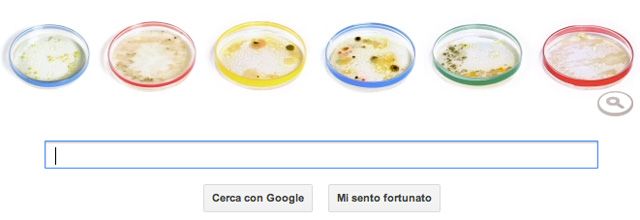

Mountain View ha deciso di dedicare un Doodle al 161° anniversario dalla nascita del microbiologo Julius Richard Petri; tedesco, nacque a Barmen nel 1852, Petri fu un allievo di Robert Koch, considerato il fondatore della batteriologia.
Il nome di questo scienziato è legato in particole alla cosiddetta piastra (o capsula) di Petri, un recipiente piatto prodotto in vetro o plastica e generalmente di forma cilindrica largamente utilizzato nelle ricerche biologiche per lo sviluppo delle colture cellulari.
E il logo di Google riadattato per l’occasione prende spunto proprio da questa particolare invenzione, le lettere del brand di Big G sono state infatti trasformate in altrettanti recipienti, ognuno destinato ad una diversa coltura che potrà essere analizzata tramite un’animazione.
Quella di Petri è considerata ancora oggi una piastra di coltura standard; adotatta anche dal suo mentore Robert Koch, grazie ad essa è stato possibile identificare negli anni numerosi batteri ritenuti responsabili della diffusione di alcune gravi malattie.

